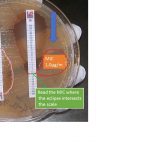
E-test of Colistin and PolymyxinB of Acinetobacter

Tag: E test
Vancomycin-Resistant Enterococcus (VRE)-Introduction, Detection Methods, and Keynotes
 Introduction of Vancomycin-Resistant Enterococcus (VRE) Vancomycin-Resistant Enterococcus (VRE) refers to strains...
Introduction of Vancomycin-Resistant Enterococcus (VRE) Vancomycin-Resistant Enterococcus (VRE) refers to strains...
Pharmaceutical Microbiology: Introduction, Course Content with Descriptions
 Pharmaceutical Microbiology Laboratory (Pharmaceutical Microbiology) B. Pharm, Second Year,...
Pharmaceutical Microbiology Laboratory (Pharmaceutical Microbiology) B. Pharm, Second Year,...
E-Test (Epsilometer Test): Introduction, Principle, Procedure, Result and Interpretation
Introduction of Epsilometer test (E-test) Epsilometer test is in brief E-test....
Introduction of Epsilometer test (E-test) Epsilometer test is in brief E-test....
